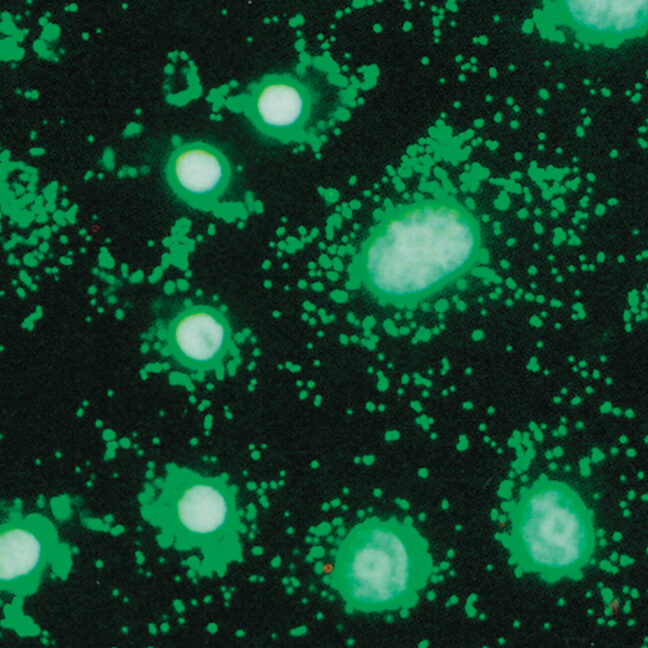

An Overview of Mycoplasma Risks, Prevention, and Management
Mycoplasma contamination is a major, often undetected problem in cell culture labs, affecting research reproducibility, slowing cell growth, and leading to unreliable results. Mycoplasma contamination can derail even the most well-controlled experiments. Proactive prevention, detection, and removal strategies are critical to ensuring successful research outcomes. This article will cover how to manage mycoplasma effectively by adopting best practices in prevention, detection, and removal. Throughout, you’ll find references to in-depth technical notes that can help implement these strategies.
- What is Mycoplasma?
- Does mycoplasma have a cell wall?
- What do mycoplasma look like?
- Is mycoplasma intracellular or extracellular?
- Why Mycoplasma Matters in Cell Culture
- How to Identify Contamination in Cell Culture
- Managing Mycoplasma: Sources, Prevention, Detection, and Removal
- Common Sources of Mycoplasma Contamination
- How to Prevent Mycoplasma Contamination
- How to Detect Mycoplasma in Cell Culture
- How to Remove Mycoplasma from Cell Culture
- Key Takeaways: Establishing a Mycoplasma Management Plan
What is Mycoplasma?
Mycoplasma is a common genus of bacteria that infects hundreds of animal species including humans. The presence of these animals in laboratories, in the form of live animals, animal-derived products, and research personnel, opens many pathways to culture contamination.
Does mycoplasma have a cell wall?
No, mycoplasma does not have a cell wall, which makes it resistant to many antibiotics, such as penicillin, that target cell wall synthesis.
What do mycoplasma look like?
Mycoplasma is one of the smallest organisms, with various species about 0.1–0.8 µm in diameter. Its lack of cell wall means that it can form many shapes. With a standard light microscope, its size and shape often lead to its misidentification as debris (small green dots at left).
MYCOPLASMA TIDBIT: Not only are mycoplasmas small in stature, but they also have small genomes. The J. Craig Venter Institute modeled the first synthetic organism with the genome of mycoplasma, reasoning that it contained a minimal set of genes required for life. The organism has been dubbed Mycoplasma laboratorium.
Is mycoplasma intracellular or extracellular?

Mycoplasma is considered extracellular. It adheres to the surface of host cells but does not invade them like some other pathogens. This adherence is the basis of its metabolic and genetic effects on mammalian cells. The danger to data posed by these cellular changes has led to international regulatory guidance specific to mycoplasma control. For more information, read our technical discussion about mycoplasma and Regulatory Compliance in Cell Culture.
Why Mycoplasma Matters in Cell Culture
This little bug is a big problem. Mycoplasma contaminates 5-30% of cell cultures globally, posing a significant risk to research projects. Here’s why:
- Extremely small size allows it to pass through filters commonly used in laboratories.
- Evades common antibiotics that target cell walls.
- Adherence to mammalian cells alters their cytokine expression and DNA repair.
- Often remains undetected for long periods.
- Can completely derail experiments if not identified and removed.
Unlike other contaminants, mycoplasma is particularly insidious, often detected too late after it has already skewed experimental data or compromised cell-based therapies, biobanking, and drug discovery processes.
For a more detailed overview of how mycoplasma contamination impacts your lab, check out our technical note: Managing Mycoplasma Contamination in Cell Culture Laboratories.
How to Identify Contamination in Cell Culture
Mycoplasma contamination is often invisible under a microscope, which makes early detection difficult without specialized techniques. Some signs of contamination may include:
- Slow or abnormal cell growth
- Changes in cell metabolism or morphology
- Increased cell death or decreased viability
For an effective detection strategy, mycoplasma testing should be routine.
Managing Mycoplasma: Sources, Prevention, Detection, and Removal
Common Sources of Mycoplasma Contamination
Mycoplasma finds its way into labs through several primary channels:
- Human-related contamination: Skin, saliva, and aerosols (especially from pipetting and centrifugation) are common vectors. Even brief lapses in aseptic technique can result in contamination.
- External contamination: Contaminated cell lines and reagents, like fetal bovine serum or media supplements, can introduce mycoplasma.
- Contaminated equipment: Incubators, water baths, and pipettes can harbor bacteria if not cleaned and decontaminated regularly.
Prevention Tip: Always quarantine new cell lines and test materials before using them in sensitive cultures.
How to Prevent Mycoplasma Contamination
Prevention is the most important line of defense. While mycoplasma can be difficult to detect, following a few best practices can minimize the chance of contamination.
Key steps to minimize risk:
1. Training staff in aseptic techniques and the risks of contamination.
2. Using certified reagents and high-quality cell lines.
3. Quarantining new cell lines and screening them before introducing them to the main lab.
4. Routinely disinfecting equipment like incubators and biosafety cabinets.
5. Testing the lab environment and identifying contamination sources.
Maintaining a strict prevention protocol ensures the reliability of your cell cultures. For a more detailed discussion on establishing an ironclad defense against mycoplasma, read our note: Effective Strategies for Preventing Mycoplasma Contamination in Cell Cultures.
How to Detect Mycoplasma in Cell Culture
Detection is often the first sign that a breach has occurred. Since mycoplasma is hard to detect through simple observation, regular screening with advanced methods is essential. Traditional detection techniques, like microscopy, often miss contamination. Modern approaches such as DNA amplification or enzymatic assays provide sensitive, specific results.
Here’s a quick comparison of rapid detection methods:
| Method | Sensitivity | Time to Results | Key Features |
| PCR | 20 CFU / mL | 3 hours | Highly sensitive |
| LAMP | 10 CFU / mL | 45 minutes | Visual confirmation |
| Enzymatic | 10 CFU / mL | 20 minutes | Detects live cells |
For effective results, it’s recommended to use multiple detection methods for independent verification. Understand and select the right detection kits by reading: Comprehensive Guide to Mycoplasma Detection Methods in Cell Cultures.
How to Remove Mycoplasma from Cell Culture
No prevention strategy is 100% foolproof, so what happens if contamination occurs? Immediate treatment is critical.
If your cell culture becomes contaminated, MP Bio’s Mycoplasma Removal Agent (MRA) has been trusted for over 40 years to save valuable cell lines. Cited in over 550 peer-reviewed publications, MRA has a proven track record of clearing contamination within one week. This is especially important for irreplaceable patient-derived cells or expensive, hard-to-source cell lines.
NOTE: Best practice includes testing the effect of any mycoplasmicidal agents on the cultured cells.
In addition to MRA, MP Bio’s Myco-Out Mycoplasma Removal Spray provides an excellent surface decontamination option to maintain lab cleanliness.
Learn how to save your contaminated cultures with our guide: Mycoplasma Removal from Contaminated Cell Culture.
Key Takeaways: Establishing a Mycoplasma Management Plan
Dealing with mycoplasma contamination is a multi-step process, but having a strong routine management procedure in place will help labs stay protected. The plan should include:
- Prevention: Train staff, maintain sterility, and use certified reagents.
- Detection: Screen regularly with advanced detection kits.
- Removal: Use MP Bio’s MRA or similar treatments at the first sign of contamination.
Proactive management will safeguard your cell-based research, ensuring experiments are accurate and reproducible. For a detailed breakdown of how to set up your lab for success, check out the full series of technical notes:
- Managing Mycoplasma Contamination in Cell Culture Laboratories
- Impact of Mycoplasma Contamination on Cell-Based Research and Applications
- Effective Strategies for Preventing Mycoplasma Contamination in Cell Cultures
- Comprehensive Guide to Mycoplasma Detection Methods in Cell Cultures
- Mycoplasma Removal from Contaminated Cell Culture
- Regulatory Compliance in Cell Culture
Staying informed and vigilant is key to protecting your valuable research from mycoplasma contamination. By following these strategies, your lab will stay on track and avoid costly mistakes.

